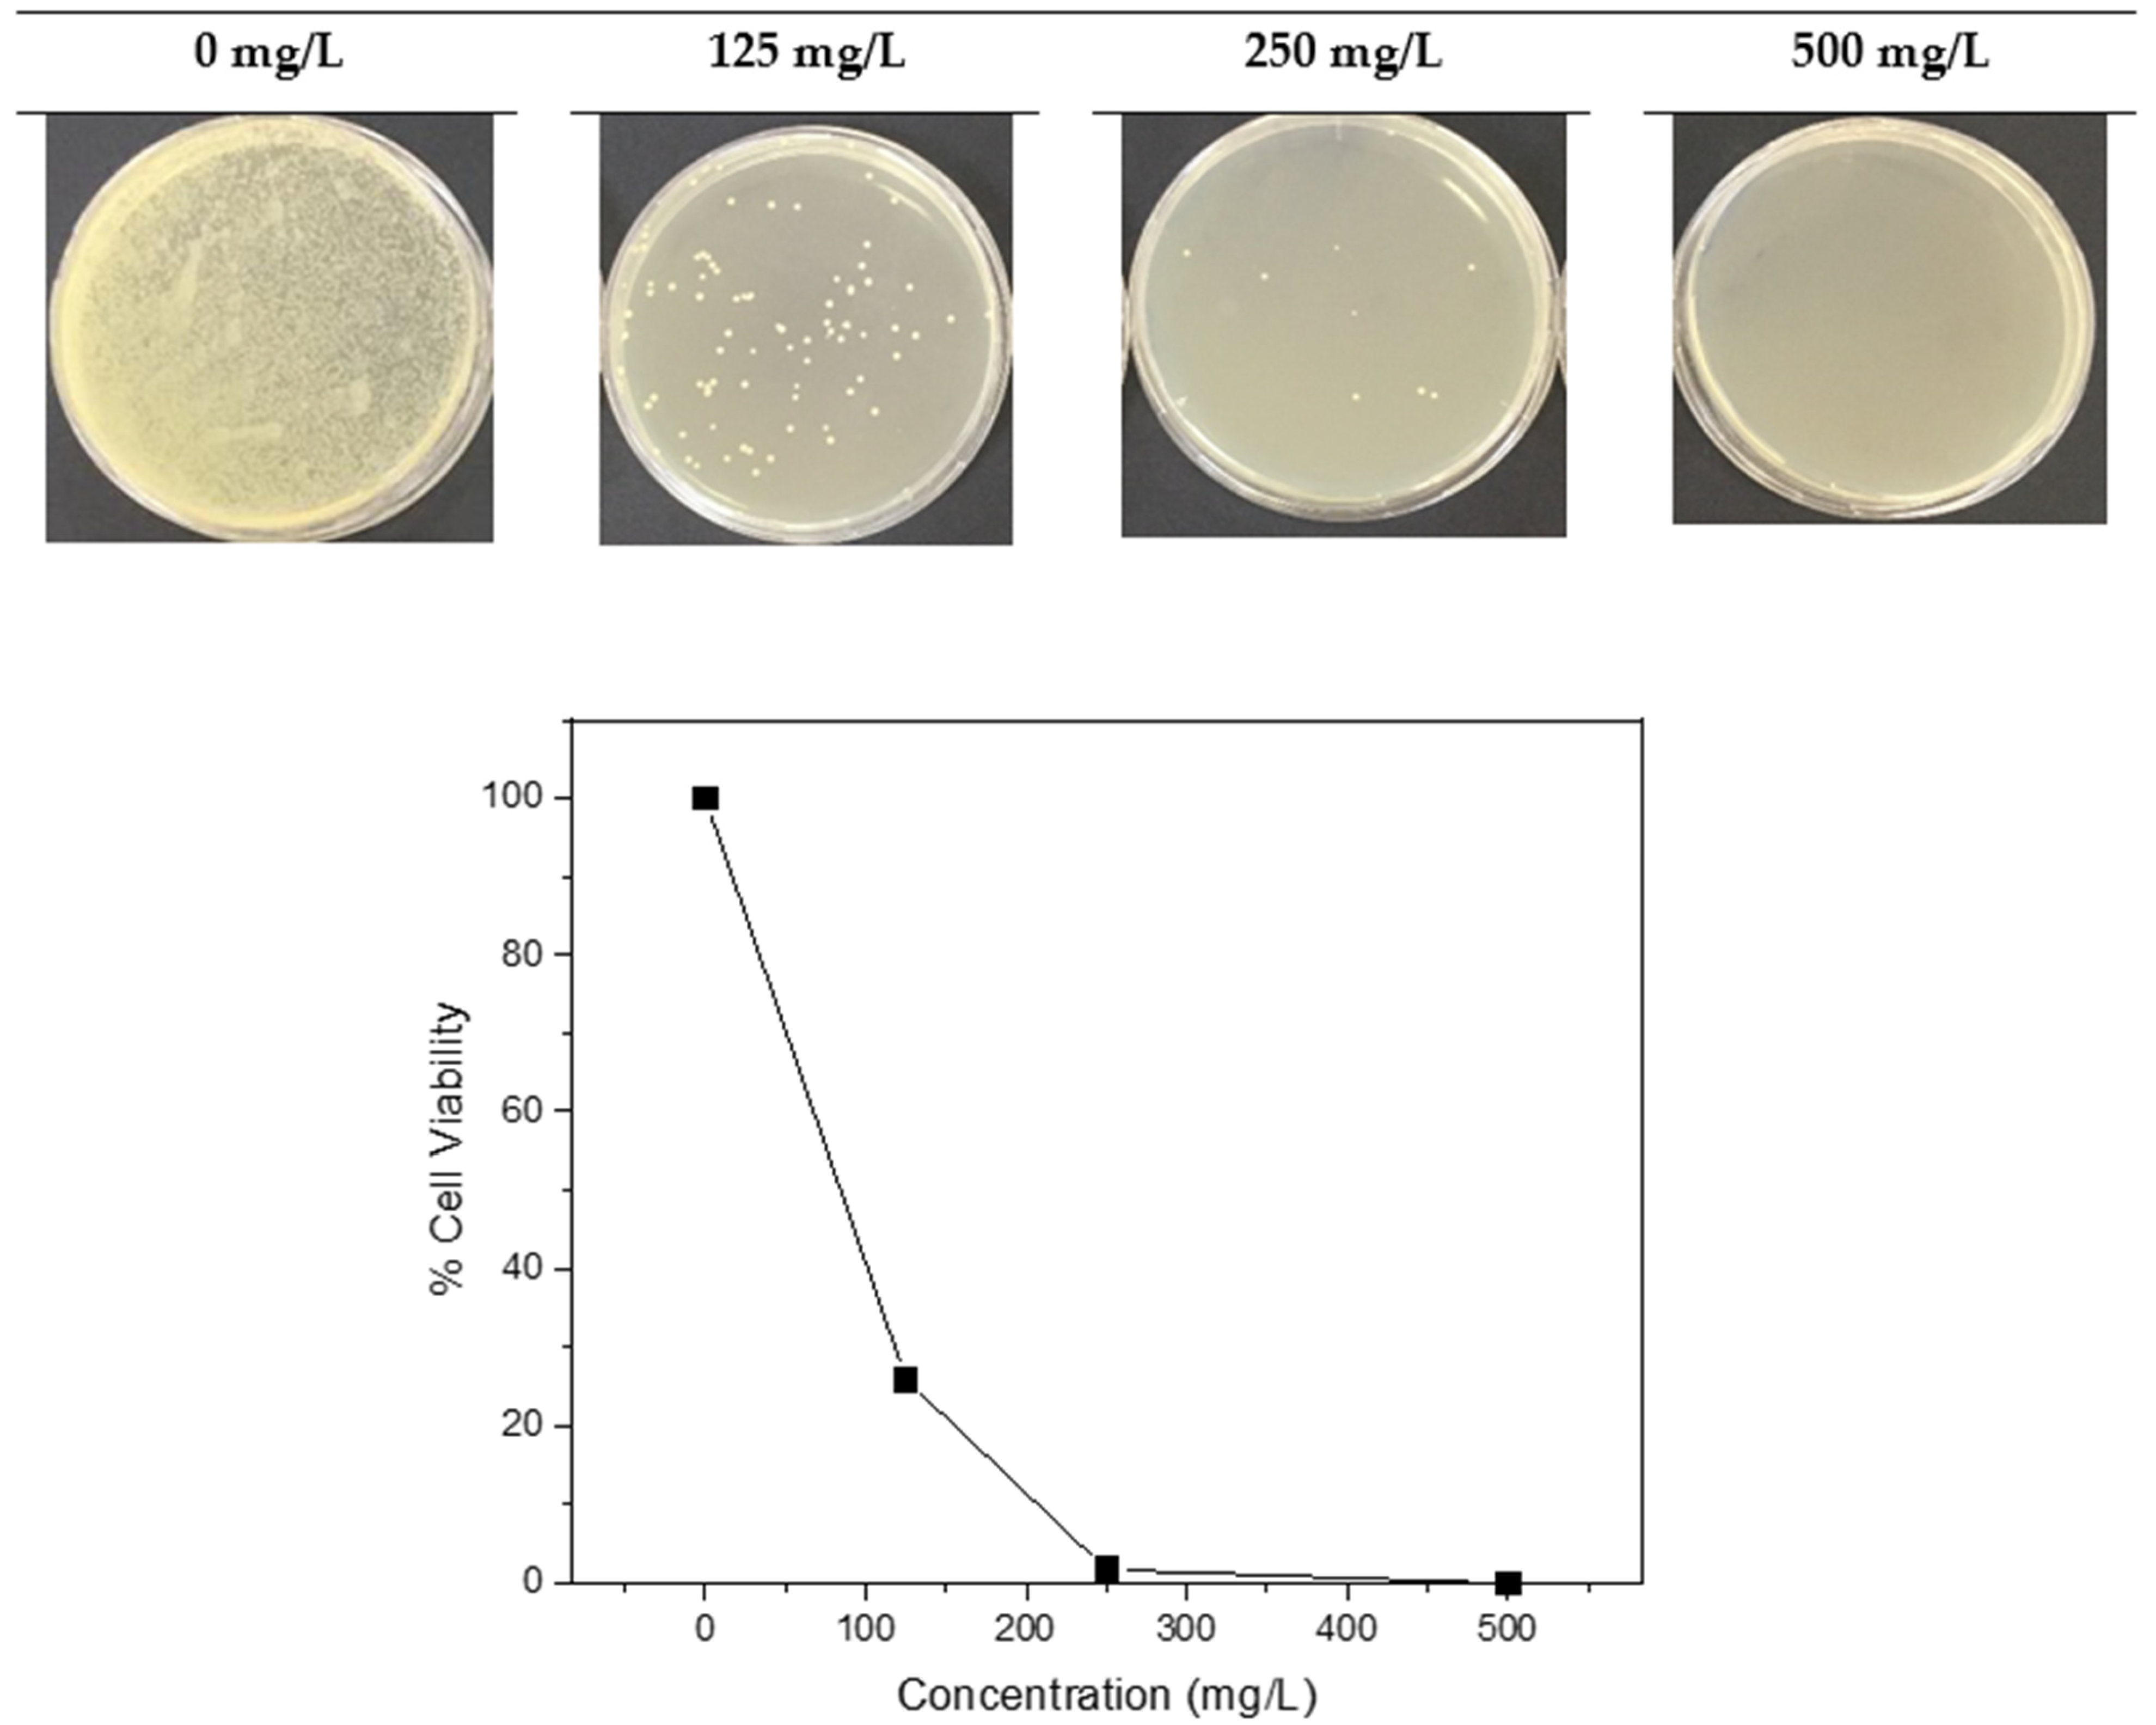
Catalysts 12 01261 g005 Catalysts 12 01261 g005
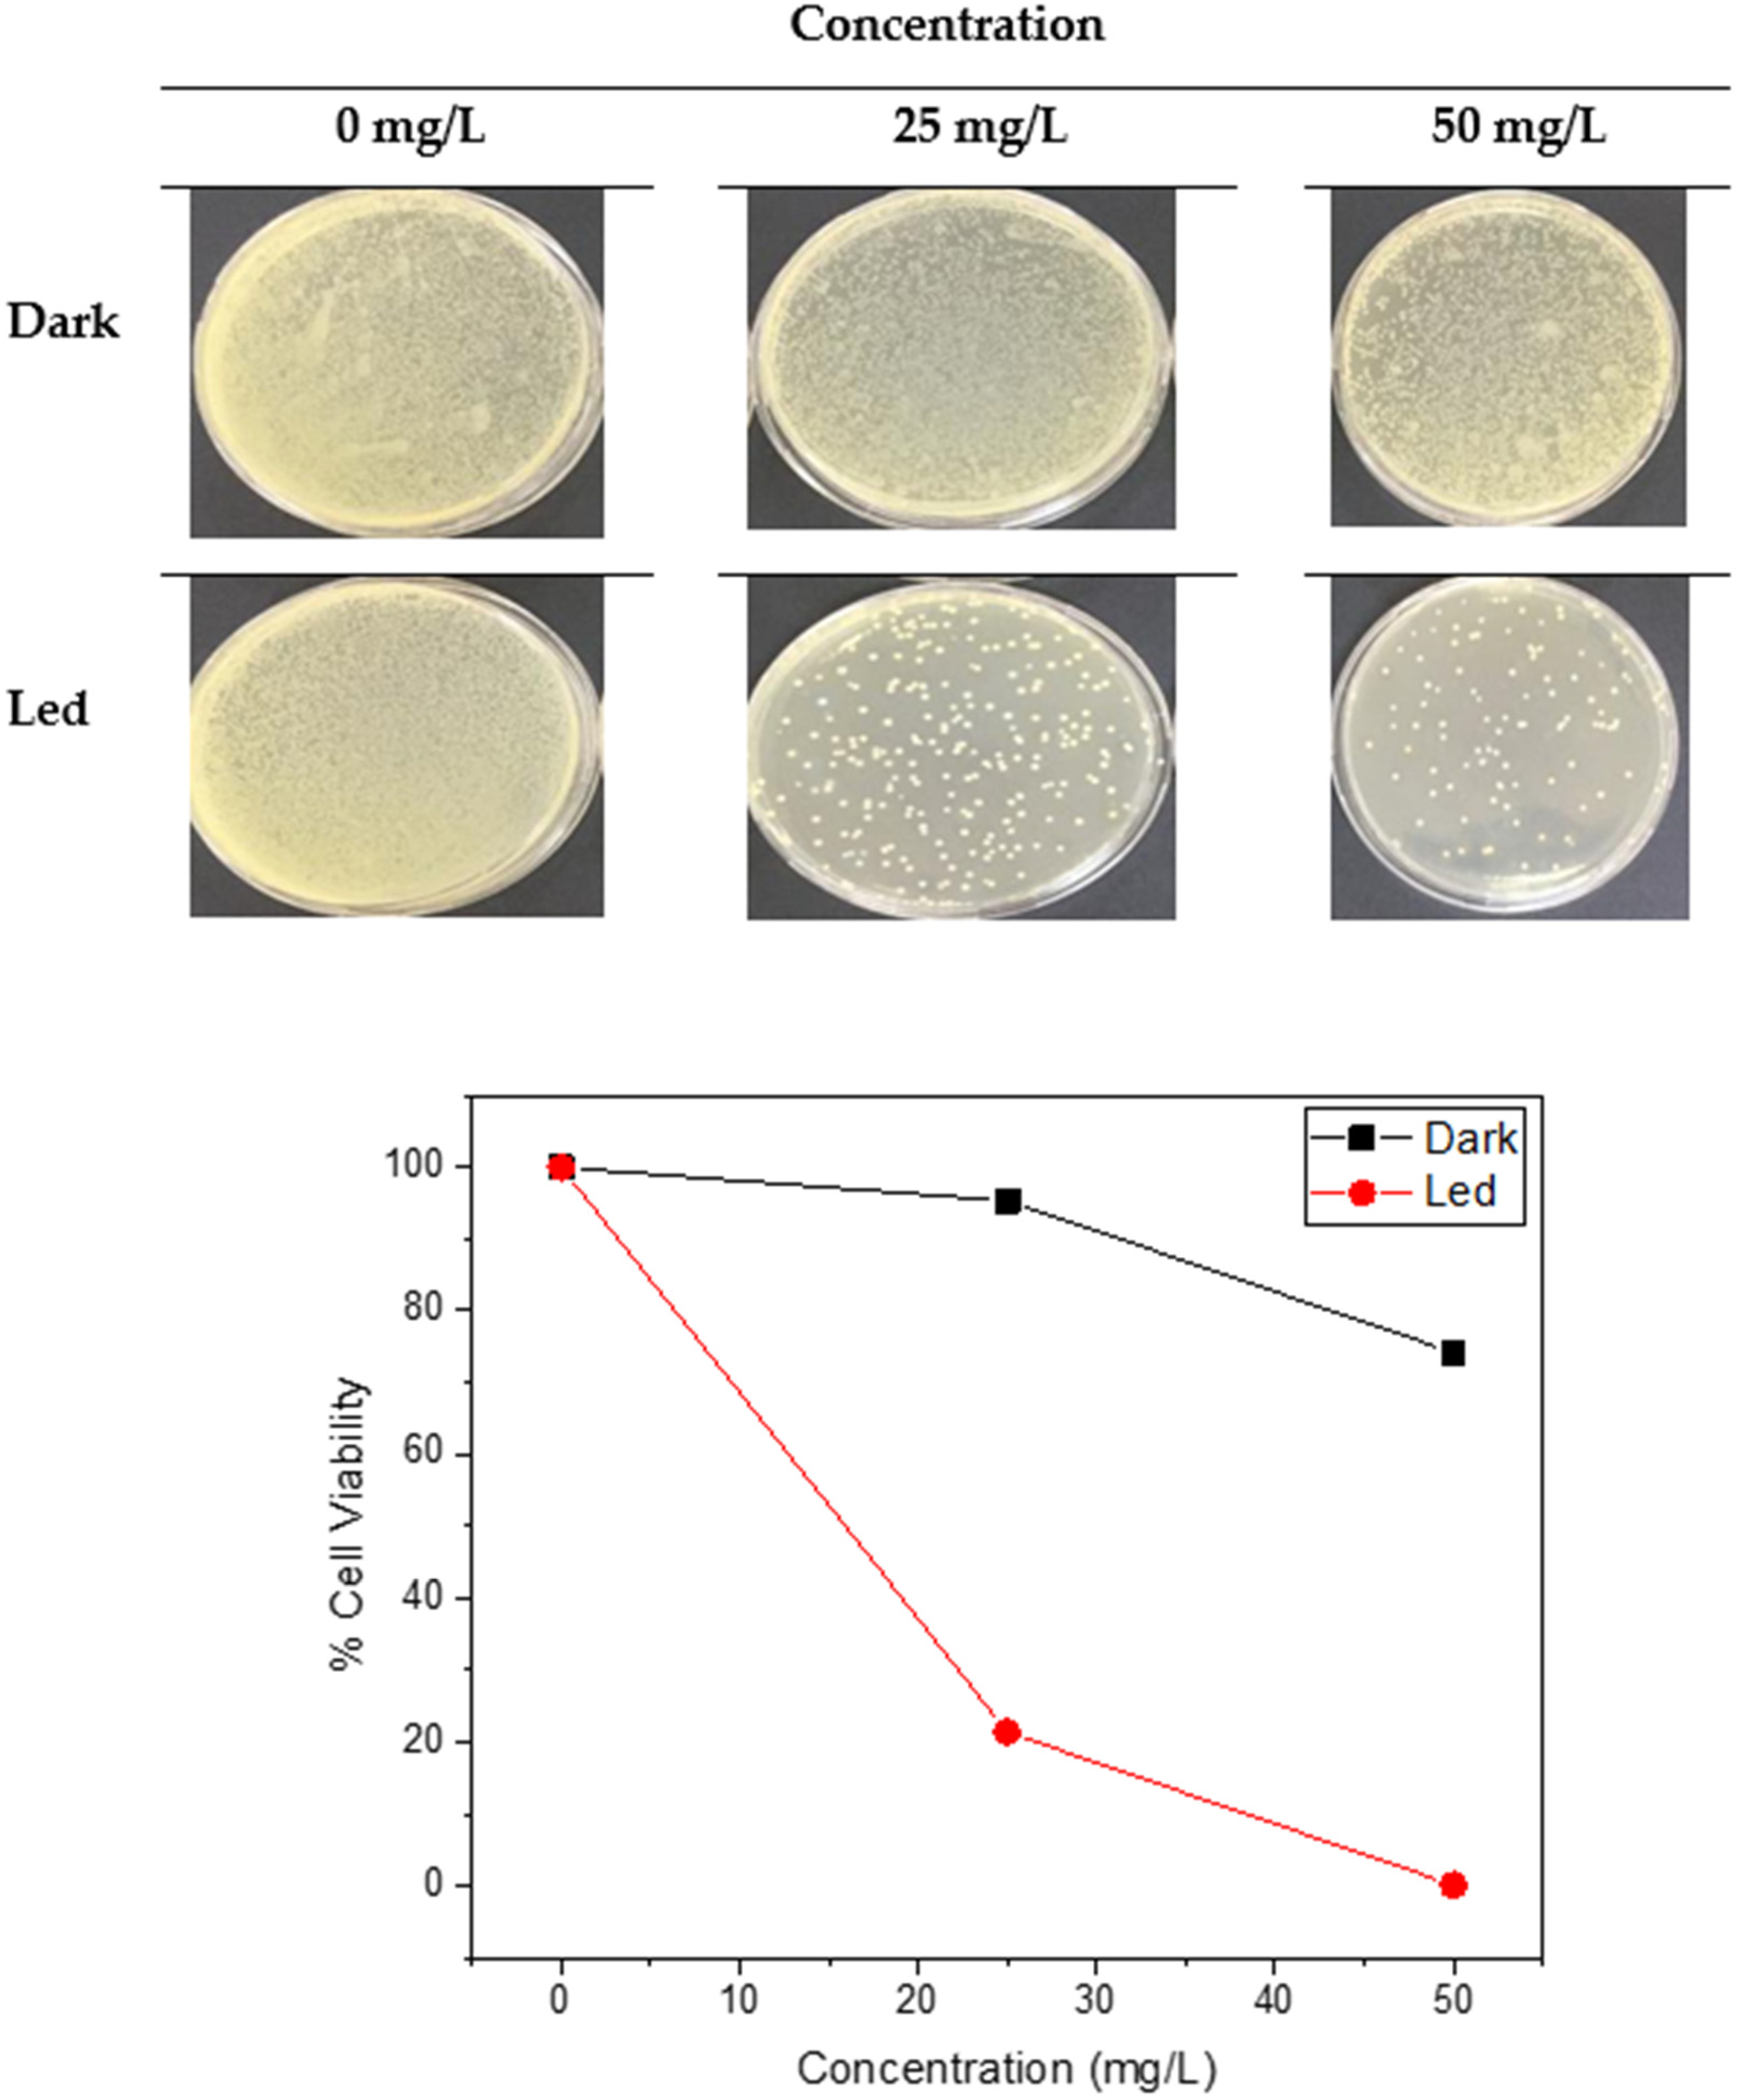
Catalysts 12 01261 g006 Catalysts 12 01261 g006

Synthesis and Characterization of a Polydioxanone-Coated Dipeptide-Functionalized Magnetic γ-Fe2O3 Nanoparticles-Modified PES Membrane and Its Biological Applications
Abstract
1. Introduction
2. Results and Discussions
2.1. Surface Characterization
2.2. Antimicrobial Properties of γ-Fe2O3-CA-Leu-Gly-PDX Nanoparticles
2.2.1. DPPH Radical Scavenging Activity of γ-Fe2O3-CA-Leu-Gly-PDX
2.2.2. Ferrous Ion Chelating Activity of γ-Fe2O3-CA-Leu-Gly-PDX
2.2.3. Antimicrobial Activity
2.2.4. DNA Cleavage Ability
2.2.5. Microbial Cell Viability
2.2.6. Antimicrobial Photodynamic Therapy by γ-Fe2O3-CA-Leu-Gly-PDX
2.2.7. Biofilm Inhibition Activity
2.3. Pristine and NPs-Blended Membrane Performance
3. Materials and Methods
3.1. Reagents and Standarts
3.2. Instrumentation
3.3. Synthesis Procedure
3.4. Characterization of γ-Fe2O3-CA-Leu-Gly-PDX
3.5. Biological Activity of γ-Fe2O3-CA-Leu-Gly-PDX Nanoparticles
3.5.1. DPPH Activity
3.5.2. Ferrous Ion Chelating Activity
3.5.3. Antimicrobial Activity
3.5.4. DNA Cleavage Ability
3.5.5. Bacterial Viability Test
3.5.6. Antimicrobial Photodynamic Therapy by γ-Fe2O3-CA-Leu-Gly-PD
3.5.7. Biofilm Inhibition Activity
3.6. Membrane Experiments
3.6.1. Preparation of γ-Fe2O3-CA-Leu-Gly-PDX-Blended PES Membrane
3.6.2. Protein Rejection Experiments of the Membranes
3.6.3. Application of γ-Fe2O3-CA-Leu-Gly-PDX-Blended PES Membrane for E. coli Removal
4. Conclusions
Author Contributions
Funding
Data Availability Statement
Acknowledgments
Conflicts of Interest
References
- Son, M.; Choi, H.; Liu, L.; Park, H.; Choie, H. Optimized synthesis conditions of polyethersulfone support layer for enhanced water flux for thin film composite membrane. Environ. Eng. Res. 2014, 19, 339–344. [Google Scholar] [CrossRef]
- Mathaba, M.; Daramola, M.O. Effect of chitosan’s degree of deacetylation on the performance of PES membrane infused with chitosan during AMD treatment. Membranes 2020, 10, 52. [Google Scholar] [CrossRef] [PubMed]
- Patil, H.; Shanmugam, V.; Marathe, K. Studies in synthesis and modification of PES membrane and its application for removal of reactive black 5 dye. Ind. Chem. Eng. 2022, 64, 111–120. [Google Scholar] [CrossRef]
- Altass, H.M.; Morad, M.; Khder, A.E.S.; Mannaa, M.A.; Jassas, R.S.; Alsimaree, A.A.; Ahmed, S.A.; Salama, R.S. Enhanced catalytic activity for CO oxidation by highly active Pd nanoparticles supported on reduced graphene oxide/copper metal organic framework. J. Taiwan Inst. Chem. Eng. 2021, 128, 194–208. [Google Scholar] [CrossRef]
- Krishnamoorthy, R.; Sagadevan, V. Polyethylene glycol and iron oxide nanoparticles blended polyethersulfone ultrafiltration membrane for enhanced performance in dye removal studies. E-polymers 2015, 15, 151–159. [Google Scholar] [CrossRef]
- Yu, M.; Renner, J.N.; Duval, C.E. A lysine-modified polyethersulfone (PES) membrane for the recovery of lanthanides. Front. Chem. 2020, 8, 512–522. [Google Scholar] [CrossRef]
- Ghaemi, N.; Madaeni, S.S.; Daraei, P.; Rajabi, H.; Zinadini, S.; Alizadeh, A.; Heydari, R.; Beygzadeh, M.; Ghouzivand, S. Polyethersulfone membrane enhanced with iron oxide nanoparticles for copper removal from water: Application of new functionalized Fe3O4 nanoparticles. Chem. Eng. J. 2015, 263, 101–112. [Google Scholar] [CrossRef]
- Kouhestani, F.; Torangi, M.A.; Motavalizadehkakhky, A.; Karazhyan, R.; Zhiani, R. Enhancement strategy of polyethersulfone (PES) membrane by introducing pluronic F127/graphene oxide and phytic acid/graphene oxide blended additives: Preparation, characterization and wastewater filtration assessment. Desalin. Water Treat. 2019, 171, 44–56. [Google Scholar] [CrossRef]
- Qadir, D.; Mukhtar, H.; Keong, L.K. Synthesis and characterization of polyethersulfone/carbon molecular sieve based mixed matrix membranes for water treatment applications. Procedia Eng. 2016, 148, 588–593. [Google Scholar] [CrossRef]
- Marjani, A.; Nakhjiri, A.T.; Adimi, M.; Jirandehi, H.F.; Shirazian, S. Effect of graphene oxide on modifying polyethersulfone membrane performance and its application in wastewater treatment. Sci. Rep. 2020, 10, 2049–2059. [Google Scholar] [CrossRef]
- Ouda, M.; Hai, A.; Krishnamoorthy, R.; Govindan, B.; Othman, I.; Kui, C.C.; Choi, M.Y.; Hasan, S.W.; Banat, F. Surface tuned polyethersulfone membrane using an iron oxide functionalized halloysite nanocomposite for enhanced humic acid removal. Environ. Res. 2022, 204, 112113. [Google Scholar] [CrossRef]
- Abidin, M.N.Z.; Goh, P.S.; Ismail, A.F.; Said, N.; Othman, M.H.D.; Hasbullah, H.; Abdullah, M.S.; Ng, B.C.; Kadir, S.H.S.A.; Kamal, F. Polysulfone/iron oxide nanoparticles ultrafiltration membrane for adsorptive removal of phosphate from aqueous solution. J. Membr. Sci. Res. 2019, 5, 20–24. [Google Scholar]
- Machodi, M.J.; Daramola, M.O. Synthesis of PES and PES/chitosan membranes for synthetic acid mine drainage treatment. Water SA 2020, 46, 114–122. [Google Scholar]
- Wen, Y.; Yuan, J.; Ma, X.; Wang, S.; Liu, Y. Polymeric nanocomposite membranes for water treatment: A review. Environ. Chem. Let. 2019, 17, 1539–1551. [Google Scholar] [CrossRef]
- Alshorifi, F.T.; Alswat, A.A.; Salama, R.S. Gold-selenide quantum dots supported onto cesium ferrite nanocomposites for the efficient degradation of rhodamine B. Heliyon 2022, 8, e09652. [Google Scholar] [CrossRef]
- Zhao, C.X.; Ran, J.; Sun, F.S. Modification of polyethersulfone membranes—A review of methods. Prog. Mater. Sci. 2013, 58, 76–150. [Google Scholar] [CrossRef]
- Ocakoglu, K.; Dizge, N.; Colak, S.G.; Ozay, Y.; Bilici, Z.; Yalcin, M.S.; Ozdemir, S.; Yatmaz, H.C. Polyethersulfone membranes modified with CZTS nanoparticles for protein and dye separation: Improvement of antifouling and self-cleaning performance. Colloids Surf. A Physicochem. Eng. 2021, 616, 126230. [Google Scholar] [CrossRef]
- Abdulkarem, E.; Ibrahim, Y.; Naddeo, V.; Banat, F.; Hasan, S.W. Development of Polyethersulfone/α-Zirconium phosphate (PES/α-ZrP) flat-sheet nanocomposite ultrafiltration membranes. Chem. Eng. Res. Des. 2020, 161, 206–217. [Google Scholar] [CrossRef]
- Vatanpour, V.; Khadem, S.S.M.; Dehqan, A.; Naqshabandi, M.A.; Ganjali, M.R.; Hassani, S.S.; Rashid, M.R.; Saeb, M.R.; Dizge, N. Efficient removal of dyes and proteins by nitrogen-doped porous graphene blended polyethersulfone nanocomposite membranes. Chemosphere 2021, 263, 127892. [Google Scholar] [CrossRef]
- Vatanpour, V.; Paziresh, S.; Dehqan, A.; Asadzadeh-Khaneghah, S.; Habibi-Yangjeh, A. Hydrogen peroxide treated g-C3N4 as an effective hydrophilic nanosheet for modification of polyethersulfone membranes with enhanced permeability and antifouling characteristics. Chemosphere 2021, 279, 130616. [Google Scholar] [CrossRef]
- Yogarathinam, L.T.; Goh, P.S.; Ismail, A.F.; Gangasalam, A.; Ahmad, N.A.; Samavati, A.; Mamah, S.C.; Abidin, M.N.Z.; Ng, B.C.; Gopal, B. Nanocrystalline cellulose incorporated biopolymer tailored polyethersulfone mixed matrix membranes for efficient treatment of produced water. Chemosphere 2022, 293, 133561. [Google Scholar] [CrossRef]
- Abbas, T.T.; Rashid, T.K.; Alsalhy, Q.F. NaY zeolite-polyethersulfone-modified membranes for the removal of cesium-137 from liquid radioactive waste. Chem. Eng. Res. Des. 2022, 179, 535–548. [Google Scholar] [CrossRef]
- Qi, G.B.; Gao, Y.J.; Wang, L.; Wang, H. Self-assembled peptide-based nanomaterials for biomedical imaging and therapy. Adv. Mater. 2018, 30, 1703444. [Google Scholar] [CrossRef]
- Park, J.; Lee, J.E.; Shin, H.J.; Song, S.; Hwang, J.S. Oral administration of glycine and leucine dipeptides improves skin hydration and elasticity in UVB-irradiated hairless mice. Biomol. Ther. 2017, 25, 528–534. [Google Scholar] [CrossRef]
- Vanhoye, D.; Bruston, F.; Amri, S.E.; Ladram, A.; Amiche, M.; Nicolas, P. Membrane association, electrostatic sequestration, and cytotoxicity of Gly-Leu-rich peptide orthologs with differing functions. Biochemistry 2004, 43, 8391–8409. [Google Scholar] [CrossRef]
- Fields, G.B. Synthesis and biological applications of collagen-model triplehelical peptides. Org. Biomol. Chem. 2010, 8, 1237–1258. [Google Scholar] [CrossRef]
- Roushenasa, P.; Yusop, Z.; Majidnia, Z.; Nasdrollahpour, R. Photocatalytic degradation of spilled oil in sea water using maghemite nanoparticles. Desalin. Water Treat. 2016, 57, 5837–5841. [Google Scholar] [CrossRef]
- Goonoo, N.; Bhaw-Luximon, A.; Jonas, U.; Jhurry, D.; Schönherr, H. Enhanced differentiation of human preosteoblasts on electrospun blend fiber mats of polydioxanone and anionic sulfated polysaccharides. ACS Biomater. Sci. Eng. 2017, 3, 3447–3458. [Google Scholar] [CrossRef]
- Bartolome, L.; Imran, M.; Lee, K.G.; Sanglang, A.; Ahn, J.K.; Kim, D.Y. Superparamagnetic γ-Fe2O3 is applied as efficient, easily recoverable, and reusable catalyst for the chemical recycling of PET via glycolysis. Green Chem. 2014, 16, 279–286. [Google Scholar] [CrossRef]
- Kılınç, E. Fullerene C60 functionalized γ-Fe2O3 magnetic nanoparticle: Synthesis, characterization and biomedical application. Artif. Cells Nanomed. Biotechnol. 2016, 44, 298–304. [Google Scholar] [CrossRef]
- Guivar, J.A.R.; Sanches, E.A.; Bruns, F.; Sadrollahi, E.; Morales, M.A.; Lopez, E.O.; Litterst, F.J. Vacancy ordered-Fe2O3 nanoparticles functionalized with nanohydroxyapatite: XRD, FTIR, TEM, XPS and Mössbauer studies. Appl. Surf. Sci. 2016, 389, 721–734. [Google Scholar] [CrossRef]
- Yang, K.K.; Wang, X.L.; Wang, Y.Z. Poly(p-dioxanone) and its copolymers. J. Macromol. Sci. E Part C—Polym. Rev. 2002, C42, 373–398. [Google Scholar] [CrossRef]
- Abdullah, J.A.A.; Eddine, L.S.; Abderrhmane, B.; Alonso-Gonzalez, M.; Romero, G.A. Green synthesis and characterization of iron oxide nanoparticles by Phoenix dactylifera leaf extract and evaluation of their antioxidant activity. Sustain. Chem. Pharm. 2020, 17, 100280. [Google Scholar] [CrossRef]
- Erci, F.; Cakir-Koc, R. Rapid green synthesis of noncytotoxic iron oxide nanoparticles using aqueous leaf extract of Thymbra spicata and evaluation of their antibacterial, antibiofilm, and antioxidant activity. Inorg. Nano-Metal. Chem. 2021, 51, 683–692. [Google Scholar] [CrossRef]
- Yeğenoğlu, H.; Aslım, B.; Güven, B.; Zengin, A.; Boyacı, İ.H.; Suludere, Z.; Tamer, İ. The comparison of antioxidant capacity and cytotoxic, anticarcinogenic, and genotoxic effects of Fe@Au nanosphere magnetic nanoparticles. Turk. J. Biol. 2017, 41, 302–313. [Google Scholar] [CrossRef]
- Shah, S.T.; Yehya, W.A.; Saad, O.; Simarani, K.; Chowdhury, Z.; Alhadi, A.A.; Al-Ani, L.A. Surface functionalization of iron oxide nanoparticles with gallic acid as potential antioxidant and antimicrobial agents. Nanomaterials 2017, 7, 306. [Google Scholar] [CrossRef]
- Madhu, G.C.; Jaianand, K.; Rameshkumar, K.; Eyini, M.; Balaji, P.; Veeramanikandan, V. Solanum tuberosum extract mediated synthesis and characterization of iron oxide nanoparticles for their antibacterial and antioxidant activity. J. Drug Deliv. Ther. 2019, 9, 15. [Google Scholar] [CrossRef]
- Rufus, N.S.; Philip, D. Synthesis of biogenic hematite (α-Fe2O3) nanoparticles for antibacterial and nanofluid applications. RSC Adv. 2016, 6, 94206–94217. [Google Scholar] [CrossRef]
- Naseem, T.; Farrukh, M.A. Antibacterial activity of green synthesis of iron nanoparticles using Lawsonia inermis and Gardenia jasminoides leaves extrac. J. Chem. 2015, 2015, 912342. [Google Scholar] [CrossRef]
- Rafi, M.M.; Ahmed, K.S.Z.; Nazeer, K.P.; Kumar, D.S.; Thamilselvan, M. Synthesis, characterization and magnetic properties of hematite (α-Fe2O3) nanoparticles on polysaccharide templates and their antibacterial activity. Appl. Nanosci. 2015, 5, 515–520. [Google Scholar] [CrossRef]
- Khalid, H.F.; Tehseen, B.; Sarwar, Y.; Hussain, S.Z.; Khan, W.S.; Raza, Z.A.; Bajwa, S.Z.; Kanaras, A.G.; Hussain, I.; Rehman, A. Biosurfactant coated silver and iron oxide nanoparticles with enhanced anti-biofilm and anti-adhesive properties. J. Hazard. Mater. 2019, 364, 441–448. [Google Scholar] [CrossRef]
- Moos, N.; Slaveykova, V.I. Oxidative stress induced by inorganic nanoparticles in bacteria and aquatic microalgae–state of the art and knowledge gaps. Nanotoxicology 2014, 8, 605–630. [Google Scholar] [CrossRef]
- Turakhia, B.; Chikkala, S.; Shah, S. Novelty of bioengineered iron nanoparticles in nano coated surgical cotton: A green chemistry. Adv. Pharmacol. Sci. 2019, 2019, 9825969. [Google Scholar]
- Shi, S.F.; Jia, J.F.; Guo, X.K.; Zhao, Y.P.; Chen, D.S.; Guo, Y.Y.; Zhang, X.L. Reduced Staphylococcus aureus biofilm formation in the presence of chitosan-coated iron oxide nanoparticles. Int. J. Nanomed. 2016, 11, 6499–6506. [Google Scholar] [CrossRef]
- Inbaraj, B.S.; Kao, T.H.; Tsai, T.Y.; Chiu, C.P.; Kumar, R.; Chen, B.H. The synthesis and characterization of poly(gamma-glutamic acid)-coated magnetite nanoparticles and their effects on antibacterial activity and cytotoxicity. Nanotechnology 2011, 22, 075101. [Google Scholar] [CrossRef]
- Chen, X.; Hu, B.; Xiang, Q.; Yong, C.; Liu, Z.; Xing, X. Magnetic nanoparticles modified with quaternarized N-halamine based polymer and their antibacterial properties. J. Biomater. Sci. Polym. Ed. 2016, 27, 1187–1199. [Google Scholar] [CrossRef]
- Niemirowicz, K.; Surel, U.; Wilczewska, A.Z.; Mystkowska, J.; Piktel, E.; Gu, X.; Namiot, Z.; Kułakowska, A.; Savage, P.B.; Bucki, R. Bactericidal activity and biocompatibility of ceragenin-coated magnetic nanoparticles. J. Nanobiotechnol. 2015, 13, 32. [Google Scholar] [CrossRef]
- Pu, L.; Xu, J.; Sun, Y.; Fang, Z.; Chan-Park, M.B.; Duan, H. Cationic polycarbonate-grafted superparamagnetic nanoparticles with synergistic dual-modality antimicrobial activity. Biomater. Sci. 2016, 4, 871–879. [Google Scholar] [CrossRef]
- Venkatesan, K.; Babu, D.R.; Bai, M.P.K.; Supriya, R.; Vidya, R.; Madeswaran, S.; Anandan, P.; Arivanandhan, M.; Hayakawa, Y. Structural and magnetic properties of cobaltdoped iron oxide nanoparticles prepared by solution combustion method for biomedical applications. Int. J. Nanomed. 2015, 10, 189–198. [Google Scholar]
- Zomorodian, K.; Veisi, H.; Mousavi, S.M.; Ataabadi, M.S.; Yazdanpanah, S.; Bagheri, J.; Mehr, A.P.; Hemmati, S.; Veisi, H. Modified magnetic nanoparticles by PEG-400-immobilized Ag nanoparticles (Fe3O4@PEG-Ag) as a core/shell nanocomposite and evaluation of its antimicrobial activity. Int. J. Nanomed. 2018, 13, 3965–3973. [Google Scholar] [CrossRef]
- Rehana, D.; Haleel, A.K.; Rahiman, A.K. Hydroxy, carboxylic and amino acid functionalized superparamagnetic iron oxide nanoparticles: Synthesis, characterization and in vitro anti-cancer studies. J. Chem. Sci. 2015, 127, 1155–1166. [Google Scholar] [CrossRef]
- Palchoudhury, S.; Xu, Y.; Rushdi, A.; Bao, Y. DNA interaction of Pt-attached iron oxide nanoparticles. IEEE Trans. Magn. 2013, 9, 373–376. [Google Scholar] [CrossRef]
- Antonoglou, O.; Lafazanis, K.; Mourdikoudis, S.; Vourlias, G.; Lialiaris, T.; Pantazaki, A.; Dendrinou-Samara, C. Biological relevance of CuFeO2 nanoparticles: Antibacterial and anti-inflammatory activity, genotoxicity, DNA and protein interactions. Mater. Sci. Eng. C 2019, 99, 264–274. [Google Scholar] [CrossRef]
- Gold, K.; Slay, B.; Knackstedt, M.; Gaharwar, A.K. Antimicrobial activity of metal and metal-oxide based nanoparticles. Adv. Therap. 2018, 1, 1700033. [Google Scholar] [CrossRef]
- Naha, P.C.; Liu, Y.; Hwang, G.; Huang, Y.; Gubara, S.; Jonnakuti, V.; Simon-Soro, A.; Kim, D.; Gao, L.; Koo, H.; et al. Dextran-coated iron oxide nanoparticles as biomimetic catalysts for localized and pH-activated biofilm disruption. ACS Nano. 2019, 13, 4960–4971. [Google Scholar] [CrossRef]
- Sathyanarayanan, M.B.; Balachandranath, R.; Srinivasulu, Y.G.; Kannaiyan, S.K.; Subbiahdoss, G. The effect of gold and iron-oxide nanoparticles on biofilm-forming pathogens. ISRN Microbiol. 2013, 2013, 272086. [Google Scholar] [CrossRef]
- Carrera, E.T.; Dias, H.B.; Corbi, S.C.T.; Marcantonio, R.A.C.; Bernardi, A.C.A.; Bagnato, V.S.; Hamblin, M.R.; Rastelli, A.N.S. The application of antimicrobial photodynamic therapy (aPDT) in dentistry: A critical review. Laser Phys. 2016, 26, 123001. [Google Scholar] [CrossRef]
- Ma, S.; Zhan, S.; Jia, Y.; Zhou, Q. Superior antibacterial activity of Fe3O4-TiO2 nanosheets under solar light. ACS Appl. Mater. Interfaces 2015, 7, 21875–21883. [Google Scholar] [CrossRef]
- Pan, W.Y.; Huang, C.C.; Lin, T.T.; Hu, H.Y.; Lin, W.C.; Li, M.J.; Sung, H. Synergistic antibacterial effects of localized heat and oxidative stress caused by hydroxyl radicals mediated by graphene/iron oxide-based nanocomposites. Nanomedicine 2016, 12, 431–438. [Google Scholar] [CrossRef]
- Thukkaram, M.; Sitaram, S.; Kannaiyan, S.K.; Subbiahdoss, G. Antibacterial efficacy of iron-oxide nanoparticles against biofilms on different biomaterial surfaces. Int. J. Biomat. 2014, 2014, 716080. [Google Scholar] [CrossRef]
- Armijo, L.M.; Wawrzyniec, S.J.; Kopicuch, M.; Brandt, Y.I.; Rivera, A.C.; Withers, N.J.; Cook, N.C.; Huber, D.L.; Monson, T.C.; Smyth, H.D.C.; et al. Antibacterial activity of iron oxide, ron nitride, and tobramycin conjugated nanoparticles against Pesudoonas aeruginosa biofilms. J. Nanobiotechnol. 2020, 18, 35. [Google Scholar] [CrossRef] [PubMed]
- Kallem, P.; Othman, I.; Ouda, M.; Hasan, S.W.; AlNashef, I.; Banat, F. Polyethersulfone hybrid ultrafiltration membranes fabricated with polydopamine modified ZnFe2O4 nanocomposites: Applications in humic acid removal and oil/water emulsion separation. Process Saf. Environ. Prot. 2021, 148, 813–824. [Google Scholar] [CrossRef]
- Zhu, L.J.; Zhu, L.P.; Jiang, J.H.; Yi, Z.; Zhao, Y.F.; Zhu, B.K.; Xu, Y.Y. Hydrophilic and anti-fouling polyethersulfone ultrafiltration membranes with poly (2-hydroxyethyl methacrylate) grafted silica nanoparticles as additive. J. Memb. Sci. 2014, 451, 157–168. [Google Scholar] [CrossRef]
- Kılınç, E. γ-Fe2O3 magnetic nanoparticle functionalized with carboxylated multi walled carbon nanotube: Synthesis, characterization, analytical and biomedical applications. J. Magn. Magn. Mater. 2016, 401, 949–955. [Google Scholar] [CrossRef]
- Martins, J.A.; Lach, A.A.; Morris, H.L.; Carr, A.J.; Mouthuy, P.A. Polydioxanone implants: A systematic review on safety and performance in patients. J. Biomater. Appl. 2020, 34, 902–916. [Google Scholar] [CrossRef]
- Goonoo, N.; Jeetah, R.; Bhaw-Luximon, A.; Jhurry, D. Polydioxanone-based bio-materials for tissue engineering and drug/gene delivery applications. Eur. J. Pharm. Biopharm. 2015, 97, 371–391. [Google Scholar] [CrossRef]
- Darezereshki, E. Synthesis of maghemite (γ-Fe2O3) nanoparticles by wet chemical method at room temperature. Mater. Lett. 2010, 64, 1471–1472. [Google Scholar] [CrossRef]
- Sousa, M.E.; Raap, M.B.F.; Rivas, P.C.; Zelis, P.M.; Girardin, P.; Pasquevich, G.A.; Alessandrini, J.L.; Muraca, D.; Sanchez, F.E. Stability and relaxation mechanisms of citric acid coated magnetite nanoparticles for magnetic hyperthermia. J. Phys. Chem. C 2013, 117, 5436–5445. [Google Scholar] [CrossRef]
- Yiu, H.H.P.; Keane, M.A. Enzyme–magnetic nanoparticle hybrids: New effective catalysts for the production of high value chemicals. Chem. Technol. Biotechnol. 2012, 87, 583–594. [Google Scholar] [CrossRef]
- Agırtaş, M.S.; Karatas, C.; Özdemir, S. Synthesis of some metallophthalocyanines with dimethyl 5-(phenoxy)-isophthalate substituents and evaluation of their antioxidant-antibacterial activities, Spectrochim. Acta A Mol. Biomol. Spectros. 2015, 135, 20–24. [Google Scholar] [CrossRef]
- Dinis, T.C.P.; Madeira, V.M.C.; Almeida, L.M. Action of phenolic derivatives (acetaminophen, salicylate, and 5-aminosalicylate) as inhibitors of membrane lipid peroxidation and as peroxyl radical scavengers. Arch. Biochem. Biophys. 1994, 315, 161–169. [Google Scholar] [CrossRef]
- Bilici, Z.; Ozay, Y.; Yuzer, A.; Ince, M.; Ocakoglu, K.; Dizge, N. Fabrication and characterization of polyethersulfone membranes functionalized with zinc phthalocyanines embedding different substitute groups. Colloids Surf. A Physicochem. Eng. 2021, 617, 126288. [Google Scholar] [CrossRef]
- Gumbi, N.N.; Hu, M.; Mamba, B.B.; Li, J.; Nxumalo, E.N. Macrovoid-free PES/SPSf/O-MWCNT ultrafiltration membranes with improved mechanical strength, antifouling and antibacterial properties. J. Memb. Sci. 2018, 566, 288–300. [Google Scholar] [CrossRef]
- Rambabu, K.; Gokul, S.; Russel, A.S.; Sivaramakrishna, A.; Ponnusami, B.; Banat, F. Lithium perchlorate modified nanoporous polyethersulfone membrane for improved dye rejection. Desalin. Water Treat. 2018, 122, 146–157. [Google Scholar] [CrossRef]
- Lowry, O.H.; Rosebrough, N.; Farr, A.L.; Randall, R.J. Protein measurement with the folin phenol reagent. J. Biol. Chem. 1951, 193, 265–275. [Google Scholar] [CrossRef]

| Microorganisms | γ-Fe2O3-CA-Leu-Gly-PDX * |
|---|---|
| E. coli | 512 |
| P. aeruginosa | 256 |
| L. pneumophila subsp. pneumophila | 256 |
| E. hirae | 128 |
| E. fecalis | 64 |
| S. aureus | 128 |
| C. parapisilosis | 128 |
| C. tropicalis | 256 |
| Membrane Sample | Mean Pore Radius (nm) | Porosity (%) | Released Iron in Permeate (µg/L) |
|---|---|---|---|
| Pristine membrane | 22.2 ± 0.5 | 58.13 ± 2.85 | - |
| NPs-blended membrane | 20.9 ± 0.4 | 61.12 ± 3.22 | 88 ± 9 |
| Material | Model Solution | NPs Amount | Main Results for Modified Membrane | Reference |
|---|---|---|---|---|
| γ-Fe2O3-CA-Leu-Gly-PDX | BSA E. coli | 1.0 wt% |
| This study |
| Fe3O4 decorated halloysite nanoclay (Fe-HNC) | Humic acid (HA) | 0.1 wt% |
| [11] |
| Polydopamine coated ZnFe2O4 | HA | 4 wt% |
| [62] |
| PHEMA-grafted SiO2 | BSA | 10 wt% |
| [63] |
Publisher’s Note: MDPI stays neutral with regard to jurisdictional claims in published maps and institutional affiliations. |
© 2022 by the authors. Licensee MDPI, Basel, Switzerland. This article is an open access article distributed under the terms and conditions of the Creative Commons Attribution (CC BY) license (https://creativecommons.org/licenses/by/4.0/).
Share and Cite
Demirci, Ö.; Gonca, S.; Tolan, V.; Özdemir, S.; Dizge, N.; Kılınç, E. Synthesis and Characterization of a Polydioxanone-Coated Dipeptide-Functionalized Magnetic γ-Fe2O3 Nanoparticles-Modified PES Membrane and Its Biological Applications. Catalysts 2022, 12, 1261. https://doi.org/10.3390/catal12101261
Demirci Ö, Gonca S, Tolan V, Özdemir S, Dizge N, Kılınç E. Synthesis and Characterization of a Polydioxanone-Coated Dipeptide-Functionalized Magnetic γ-Fe2O3 Nanoparticles-Modified PES Membrane and Its Biological Applications. Catalysts. 2022; 12(10):1261. https://doi.org/10.3390/catal12101261
Chicago/Turabian StyleDemirci, Özlem, Serpil Gonca, Veysel Tolan, Sadin Özdemir, Nadir Dizge, and Ersin Kılınç. 2022. "Synthesis and Characterization of a Polydioxanone-Coated Dipeptide-Functionalized Magnetic γ-Fe2O3 Nanoparticles-Modified PES Membrane and Its Biological Applications" Catalysts 12, no. 10: 1261. https://doi.org/10.3390/catal12101261
APA StyleDemirci, Ö., Gonca, S., Tolan, V., Özdemir, S., Dizge, N., & Kılınç, E. (2022). Synthesis and Characterization of a Polydioxanone-Coated Dipeptide-Functionalized Magnetic γ-Fe2O3 Nanoparticles-Modified PES Membrane and Its Biological Applications. Catalysts, 12(10), 1261. https://doi.org/10.3390/catal12101261

